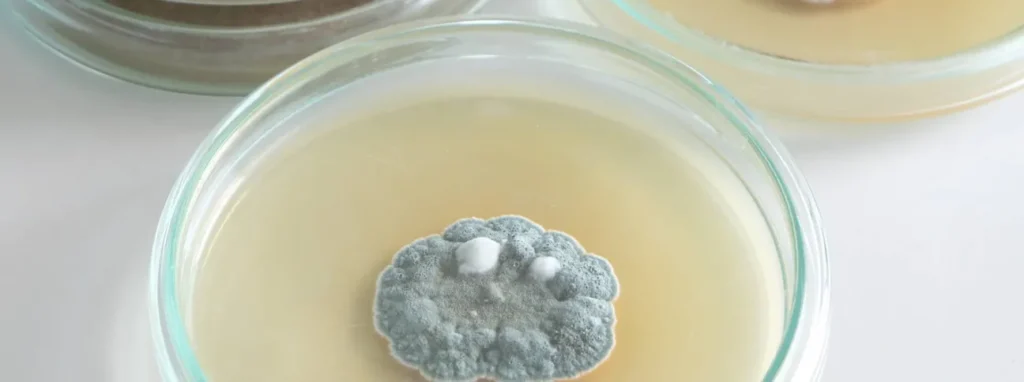

Tre errori fortunati: quando lo sbaglio si trasforma in genio
Nonostante nella scienza, siamo abituati a pensare che il successo sia il risultato di una pianificazione rigorosa, la storia è piena di momenti in cui il destino ha deciso di premiare il caos. Questi sono i “serendipity“: casi in cui un ricercatore cercava una cosa e ne ha trovata una migliore, cambiando per sempre il corso della storia.
Ecco tre degli errori più fortunati di sempre.
La muffa che salvò il mondo: la Penicillina
Il biologo scozzese Alexander Fleming non era esattamente un fanatico dell’ordine. Nel 1928, prima di partire per le vacanze infatti, dimenticò di pulire alcune piastre di Petri contenenti colture di batteri stafilococchi.
Al suo ritorno, notò qualcosa di strano: una muffa verde aveva iniziato a crescere in una delle piastre. Invece di limitarsi a buttare via tutto, decise di studiare la cosa e notò che, intorno alla muffa, i batteri erano stati dissolti. Osservò che un contaminante fungino stava influenzando la crescita dei batteri vicini. Il fungo si rivelò essere P. notatum e la molecola antibatterica che produceva fu chiamata penicillina. Fleming registrò le sue osservazioni nell’articolo sul The British Journal of Experimental Pathology nel 1929, dove dimostrò che la penicillina è in grado di inibire la crescita batterica in vitro.
- L’errore: Una finestra lasciata aperta e una pulizia trascurata.
- Il risultato: La nascita del primo antibiotico, una scoperta che ha salvato circa 200 milioni di vite da allora.
Un’esplosione in tasca: il forno a microonde

Nel 1945, l’ingegnere Percy Spencer stava lavorando sui magnetron per i radar militari della Raytheon. Mentre si trovava vicino a un apparato attivo, sentì una strana sensazione di calore in tasca. Con sua grande sorpresa, scoprì che la tavoletta di cioccolato che portava con sé si era sciolta.
Invece di pulirsi i pantaloni e basta, Spencer volle capire cosa fosse successo. Provò quindi a fare lo stesso con dei pop corn, aumentando la potenza del magnetron, ed essi saltarono velocemente in tutta la stanza. Provò quindi con un uovo, che esplose. Lo sviluppo di quello che sarebbe diventato il moderno forno a microonde continuò, e nel 1947, la Raytheon commercializzò i primi macchinari di questo tipo. Nel 1955 venne costruito il primo forno per uso casalingo.
- L’errore: Un incidente di percorso durante lo sviluppo di tecnologie belliche.
- Il risultato: Il forno a microonde, oggi presente in quasi tutte le cucine del pianeta.
L’adesivo che non incollava: i Post-it

Nel 1968, Spencer Silver, un chimico della 3M, stava cercando di inventare una super-colla per l’industria aerospaziale. Il risultato fu un disastro: la colla era così debole che poteva essere staccata con un dito senza lasciare residui. Per anni, la 3M considerò quella formula un fallimento inutile.
La svolta arrivò grazie a un collega, Arthur Fry che, stanco di perdere il segno nel suo libro di canti in chiesa perché i segnalibri cadevano continuamente, si ricordò della “colla fallimentare” di Silver.
- L’errore: Cercare una colla permanente e ottenere una colla temporanea.
- Il risultato: Il Post-it, uno degli oggetti da ufficio più iconici e venduti al mondo.
In conclusione: perchè i tre errori fortunati funzionano?
Questi casi ci insegnano che la fortuna aiuta solo chi è pronto a osservarla. Fleming avrebbe potuto buttare la piastra sporca e Spencer avrebbe potuto semplicemente cambiare i pantaloni, ma la loro grandezza non è stata l’errore in sé, ma la curiosità di chiedersi: “Perché è successo?”




Comments are closed, but trackbacks and pingbacks are open.